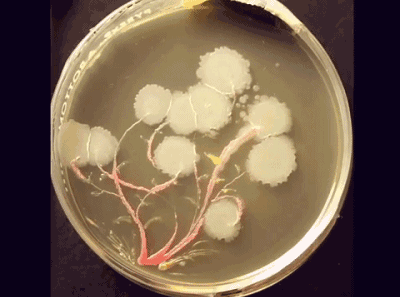

“你在一天中能遇到多少生物?”
如果問普通人這個問題,他們可能第一時間會想到平時遇到的人類、小飛蟲、寵物或者路邊的植物。
但是對于我們——生物行業(yè)的人來說,那答案太多了:除了天上飛的、地上爬的、水里游的,還有空氣中飄的呢!
畢竟相比于普通人,我們可是用顯微鏡窺探過微觀世界的人啊。我們“生物佬”的眼中除了廣闊的天地萬物,還有滾滾紅“塵”——那里有肉眼看不見的微生物世界。
它們存在于地面和皮膚、雨水和粘膜里,甚至能形成氣溶膠懸浮在空中,數(shù)量極為龐大。
這龐大的數(shù)量多半和微生物強大的繁殖能力有關(guān)。凡是和生物學(xué)沾點邊兒的學(xué)科,都會安排大腸桿菌接種的實驗。
將極小的一點大腸桿菌細胞作為種子劃線接種在培養(yǎng)基上,然后放在與人體溫度相仿的培養(yǎng)箱中過夜培養(yǎng)。第二天就可以收獲滿滿一層覆蓋在培養(yǎng)基上的大腸桿菌。
盡管我們?nèi)庋劭磥硭鼈兇笮〔贿^一個培養(yǎng)基,但實際上這一個培養(yǎng)基上的大腸桿菌數(shù)量已經(jīng)了超過100億。它們都源于剛開始那一小點的大腸桿菌。雖然這是在實驗室環(huán)境下的理想情況,但微生物繁殖能力之強,可見一斑。
既然我們無法數(shù)清一天之中遇到的微生物,那么不妨縮小觀察范圍:
一個房間里面有多少的微生物?
耶魯?shù)囊豁椦芯繑?shù)據(jù)表明:一個有人活動的30平方教室中,平均每小時會增加3700萬個細菌和730萬個真菌。(注1)考慮到由30億個細胞組成的人類身體同時也容納了100萬億個細菌及真菌,幾千萬個微生物通過人類的呼吸、毛屑掉落等方式被釋放到房間中也就不足為奇了。

這些種類繁多的微生物中還會趨向于生活在一起,通過一種稱為生物膜的膠質(zhì)結(jié)構(gòu)以提高對惡劣環(huán)境的抗性。他們在生物膜內(nèi)分層而居,有些層的微生物執(zhí)行光合作用,有些層呼吸氧氣,有些進行發(fā)酵,有些還可以利用環(huán)境中的無機物質(zhì)。所謂甲之砒霜乙之蜜糖,相互利用各自的代謝物互利共生。憑借這種作用機制,微生物就能夠在不利環(huán)境中生存下去。
近期,NASA發(fā)現(xiàn)航天器雖然經(jīng)過嚴格的消毒,仍然會將部分的微生物帶離地球。其中一些不動桿菌不但逃過消毒劑的殺滅,還學(xué)會了從乙醇上獲得能量,并利用里面的碳合成自身的結(jié)構(gòu)。(注2)

但是,盡管微生物的繁殖能力和生存能力都十分強,我們?nèi)梭w的防御系統(tǒng)也不是泥糊的。人體最大的器官皮膚能分隔身體的內(nèi)外環(huán)境,與外界相通的消化系統(tǒng)也會分泌各種對微生物殺滅效果顯著的消化液,大部分的微生物都能與人和諧共處。少量致病菌一旦進入人體也會被免疫系統(tǒng)殺滅。
然而無菌藥品就不一樣了,其中很多劑型的藥物可以繞過皮膚,直接進入人體。
試想一下,若原本應(yīng)該無菌的藥品上攜帶了微生物.....
病人的免疫力本來就處于被消耗的狀態(tài),一旦增加微生物進入體內(nèi),風(fēng)險會非常高。所以,各國的藥監(jiān)部門自然會對無菌藥品的原輔料、成品含有的微生物、制藥環(huán)節(jié)中的環(huán)境微生物等方面提出極高的要求。其中環(huán)境微生物的來源眾多,難免會出現(xiàn)一般消毒方式難以徹底殺滅的微生物。(畢竟NASA都在航天器上發(fā)現(xiàn)了微生物啊......)
因此各國法規(guī)條文中就有了:
“消毒程序應(yīng)該包含定期對微生物孢子的殺滅。”(注3)
“ 可采用熏蒸的方法降低潔凈區(qū)內(nèi)衛(wèi)生死角的微生物污染”(注4)
提示要注意難殺滅微生物對無菌制藥的風(fēng)險。
作為對一般消毒的周期性補充,廣州東弘針對高等級滅菌的需要,推出了使用干霧式過氧化氫復(fù)合配方的空間滅菌產(chǎn)品:DF潔凈空間滅菌系統(tǒng)。


使用氣態(tài)滅菌的方式,不留任何消毒死角,面對難以殺滅的孢子體也達到下降6log的滅菌效果,可替代傳統(tǒng)的甲醛、臭氧、 VHP(汽化過氧化氫)等滅菌方法。
注1:
https://onlinelibrary.wiley.com/doi/full/10.1111/j.1600-0668.2012.00769.x
注2:
http://tech.huanqiu.com/discovery/2018-06/12201573.html
注3:FDA Guidance for Industry Sterile Drug Products Produced by Aseptic Processing —Current Good Manufacturing Practice X.A.Environmental Monitoring
注4:GMP2010 無菌制藥附錄 第九章
更多技術(shù)資訊,請關(guān)注東銳科技



瀏覽次數(shù):1
日期:2018.11.06










